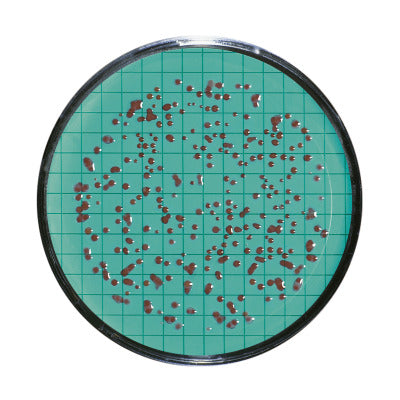

SUBSCRIBE TO OUR NEWSLETTER
Register now to get updates on promotions and coupons.

The site owner may have set restrictions that prevent you from accessing the site. Please contact the site owner for access.



Estimated Delivery
Jun 15 - Jun 22
Couldn't load pickup availability
Free standard shipping on orders over $50

Standard TTC Nutrient Pad Sets for total colony count, 100 NPS in petri dishes, with 100 sterile membranes
Sartorius Nutrient Pad Sets have been used successfully in the membrane filter method for more than 30 years. Practical and easy to handle, Nutrient Pads reduce labor and simplify many microbiological testing procedures. Microorganisms require the appropriate culture media for optimal growth. Nutrient Pad Sets are dehydrated culture media. Once they are moistened with 3.0 – 3.5 ml of sterile and demineralized (or pure ) water they are ready-to-use immediately. The level of moisture is optimal when an excess ring of water surrounding the NPS is visible.
The standard NPS box contains 100 Nutrient Pads, each of which is individually inserted in a petri dish. Ten each of these petri dishes are sealed in an aluminum bag. This special packaging in bags protects the sensitive formula constituents of the Nutrient Pad during transport and storage from fluctuations in humidity and temperature. As a result, it guarantees the high quality of our NPS throughout their entire shelf life up to 24 months. This makes the Sartorius Nutrient Pads Sets unique: No other ready-to-use culture media around the globe assures such consistently high quality and reproducible results up to 24 months.
Compliance with International Standards: Currently, Sartorius offers more than 30 different Nutrient Pad Set types to meet the diverse requirements of microbiological analysis. Aside from the European drinking water directive, they comply with other international regulations and recommendations: international pharmacopoeias, DIN and ISO standards, the American Standards for Water and Foods, mineral water regulations, brewery guidelines, such as MEBAC or EBC, and recommendations of the food industry, such as LMBG, NCA and ICUMSA, etc.
Includes Membrane Filters: All Nutrient Pad Set types are supplied with the appropriate membrane filters, which are individually sterile packaged. Nutrient Pad Sets are also available with Microsart® e.motion Membrane Filters which are specially designed for the Microsart® e.motion Dispenser and can be conveniently inserted. The membrane filters are then automatically removed from their sterile package. All membrane filters, tailored to meet the special requirements of microbial detection, are available with 47 or 50 mm diameter.

